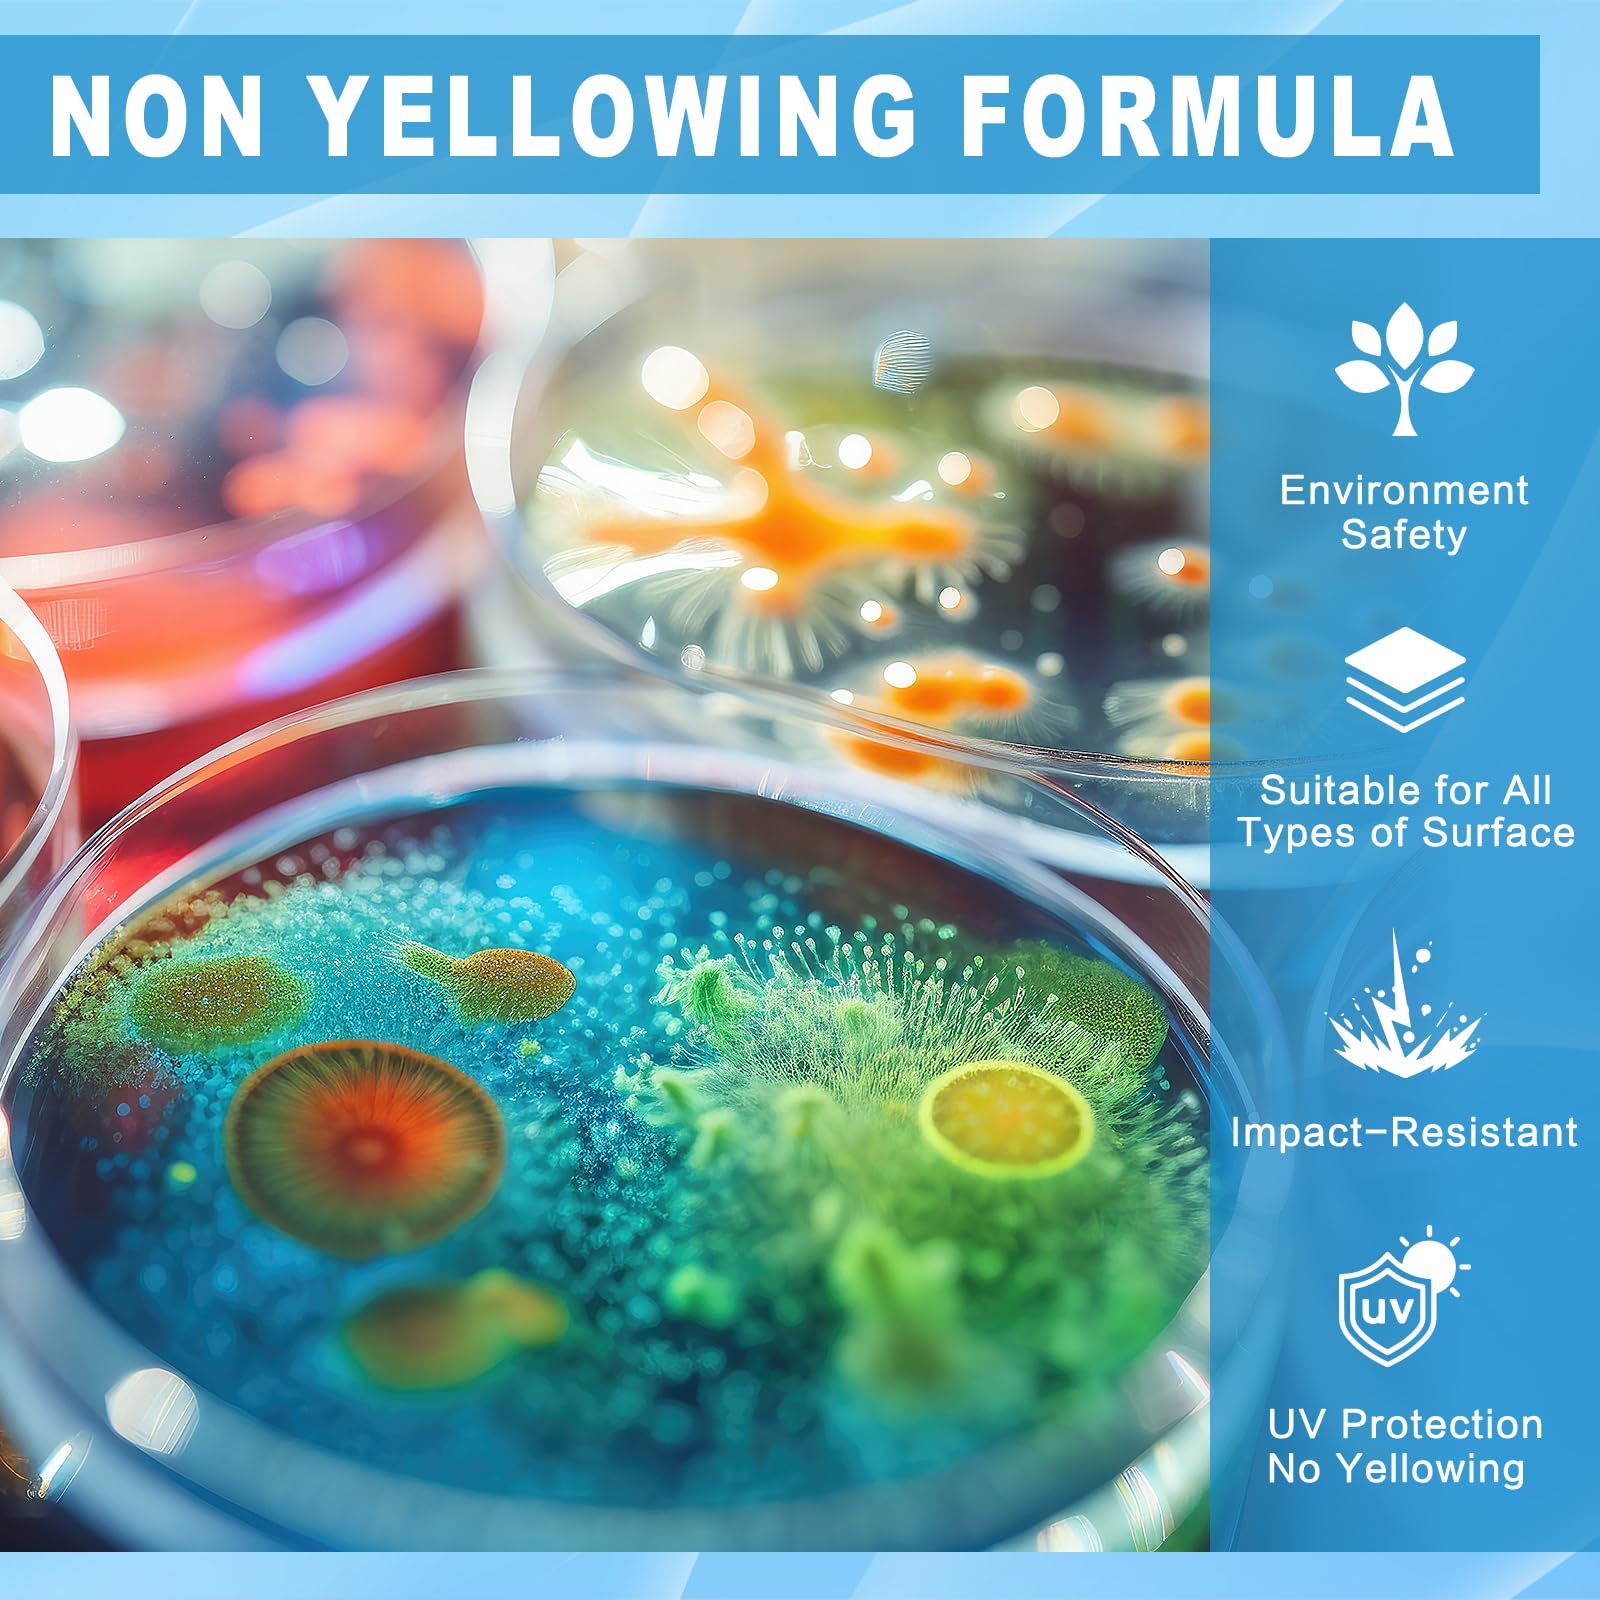
Thumbnail 5

✨ Elevate your art with flawless, rock-hard shine! 💎
WYCOON Epoxy Resin 68OZ offers a crystal-clear, non-toxic, and bubble-free casting experience with a rock-hard finish (hardness 85). Featuring a user-friendly 1:1 mixing ratio, 40-minute work time, and full cure in 24 hours, it resists yellowing and is waterproof and scratch-proof. Perfect for professional and beginner artists alike, it comes as a complete kit with tools and a 12-month warranty, ideal for jewelry making, river tables, coatings, and diverse creative projects.

| Brand | WYCOON |
| Model Number | WY100013 |
| Colour | Clear |
| Package Dimensions | 30.2 x 16.9 x 16.5 cm; 2.64 kg |
| Material | Resin, Epoxy Resin Epoxy |
| Special Features | Waterproof |
| Item Weight | 2.64 kg |
P**
Works really well
Not for personal use , but I am told excellent product . No hassle resin
K**.
Ease of use
Used by myself to seal a lock of hair from my grandson's 1st hair cut
F**D
Resin kit
Baught to repair a floorResin berry runny and settled without bubbles, settled well and seems ok and clear
R**.
Resin art
Perfect!
R**D
Very good
The media could not be loaded. Very good quality
N**S
They should make shure the lids should be checked that they are tiyt and arows are on the box
The bottles had leaked all in the box because the lids wasn't closed properly plus thier was no arrows on the box to say witch way the box should stand so I'm not blaming the delivery driver for it
G**T
Good performance
Clear and no bubbles. Highly recommended.
M**Y
Awesome
Great product, fast delivery
Trustpilot
1 day ago
2 months ago